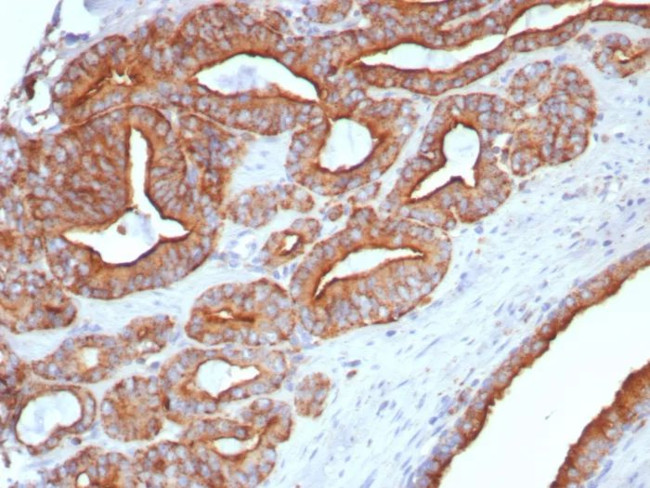
CD107a/Lysosomal associated membrane protein 1 (LAMP1) Antibody in Immunohistochemistry (Paraffin) (IHC (P))
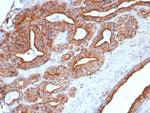
CD107a/Lysosomal associated membrane protein 1 (LAMP1) Antibody in Immunohistochemistry (Paraffin) (IHC (P))

Search
NeoBiotechnologies
CD107a/Lysosomal associated membrane protein 1 (LAMP1) Monoclonal Antibody (LAMP1/7458)
{{$productOrderCtrl.translations['antibody.pdp.commerceCard.promotion.promotions']}}
{{$productOrderCtrl.translations['antibody.pdp.commerceCard.promotion.viewpromo']}}
{{$productOrderCtrl.translations['antibody.pdp.commerceCard.promotion.promocode']}}: {{promo.promoCode}} {{promo.promoTitle}} {{promo.promoDescription}}. {{$productOrderCtrl.translations['antibody.pdp.commerceCard.promotion.learnmore']}}
产品信息
3916-MSM3-P1ABX
种属反应
宿主/亚型
分类
类型
克隆号
抗原
偶联物
形式
浓度
规格
纯化类型
保存液
内含物
保存条件
运输条件
产品详细信息
Positive Control: Human tonsil kidney or prostate. Placenta
Cellular Location: Cytoplasm. Cell membrane.
靶标信息
LAMP1 (CD107a, lysosome-associated membrane protein-1) together with LAMP-2, is a major constituent of lysosomal membrane, 1-2% of total CD107a is found also on the plasma membrane. LAMP1 is a heavily glycosylated membrane protein which contains a putative signal peptide, 18 sites for N-linked glycosylation, a single membrane-spanning segment and a short (11 amino acid) cytosolic tail. The LAMP proteins are involved in lysosome biogenesis and are required for fusion of lysosomes with phagosomes. LAMP1 is a type 1 integral membrane protein that is transported from trans-Golgi network to endosomes and then lysosomes. Upon cell activation, LAMP1 transfer to the plasma membrane is dependent on a carboyxl-terminal tyrosine based motif (YXXI). Perturbation in the spacing between the tyrosine based motif relative to the membrane abolishes lysosome localization of LAMP1, and this mutant protein then cycles between the plasma membrane and the endosome. Cell surface LAMP1 (and LAMP2) have been shown to promote adhesion of human peripheral blood mononuclear cells (PBMC) to vascular endothelium, therefore, they are possibly involved in the adhesion of PBMC to the site of inflammation. Increased LAMP1 immunoreactivity is observed in neurons and glial cells surrounding senile plaques in Alzheimer's Disease (AD) cases, and is localized in medullary epithelial cells, single macrophages and lymphocytes in acute thymic involution. LAMP1 is a good marker of mast cell activation.
仅用于科研。不用于诊断过程。未经明确授权不得转售。
篇参考文献 (0)
生物信息学
蛋白别名: CD107 antigen-like family member A; CD107a; LAMP-1; Lysosome-associated membrane glycoprotein 1; lysosome-associated membrane protein 1; membrane glycoprotein; unnamed protein product
基因别名: CD107a; LAMP1; LAMPA; LGP120
UniProt ID: (Human) P11279
Entrez Gene ID: (Human) 3916